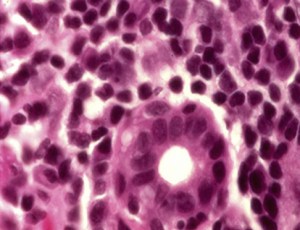
Accesory salivary gland in a patient with GVHD.png

Management of Ocular GVHD
All content on Eyewiki is protected by copyright law and the Terms of Service. This content may not be reproduced, copied, or put into any artificial intelligence program, including large language and generative AI models, without permission from the Academy.
Management
Careful history and physical examination are critical to distinguish between graft versus host disease (GVHD) associated ocular surface problems and other causes of dry eye disease. Awareness by primary teams and ophthalmology teams in the hospital setting facilitate early evaluation and treatment of patients with ocular GVHD [1].
The National Institutes of Health formulated consensus guidelines with 4 major supportive care goals for ocular GVHD [2].
- Lubrication
- Control of tear evaporation
- Control of tear drainage
- Decrease of ocular surface inflammation
Treatment modalities need to be matched to each patient’s particular symptoms.
General treatment
Treatment for ocular GVHD is comparable to other severe types of dry eye. Clinicians need to understand the status of a patient’s systemic GVHD since this may influence the treatment strategy [3]. Topical steroids are often used earlier for ocular GVHD than they would for other causes of dry eye. Cautious use and monitoring are warranted with use of topical steroids due to increased risk of steroid-related complications such as elevated intraocular pressure, cataracts, and infectious keratitis.
Medical therapy
Systemic immunosuppressive therapy and local therapy are routinely used for the treatment of graft versus host disease [1]. Treatments for manifestations of ocular GVHD are based on its severity. First-line therapy includes preservative-free artificial tears to promote lubrication, improve superficial punctate keratitis, and protect the ocular surface [3]. Topical steroids reduce ocular surface inflammation and formation of cicatricial changes in chronic ocular GVHD [2]. Because of the increased risk of infections, cataract, and increased intraocular pressure with topical steroids, research is ongoing for other immunosuppressive agents [4]. Topical cyclosporine (Restasis) improves corneal sensitivity, goblet cell density, and tear function in ocular GVHD [5]. A recent small retrospective cohort study (n=18) also examined the use of lifitigrast 5% (Xiidra) in patients with keratoconjunctivitis siccca secondary to ocular GVHD, and found it to be well-tolerated in 83% of patients and efficacious in 44% in improving NIH severity scores. [6]. Tacrolimus, another calcineurin inhibitor, has also demonstrated possible efficacy in ocular GVHD as both a systemic and topical medication, though adverse reactions must be monitored for with long term use.[7].
In the presence of meibomian glandular dysfunction, tear evaporation and breakup can be reduced with warm compresses. Increased humidity, moisture goggles, and nutritional supplements such as fish oil may also be effective [3]. Oral doxycycline can be useful in the setting of moderate to severe meibomian gland dysfunction due to its anti-inflammatory and antibiotic effects; however benefits of treatment must be weighed against its potential side-effects. Autologous eye drops contain growth factors and vitamins that support the healing and integrity of the ocular surface [8]. Scleral contact lenses and prosthetic replacement of the ocular surface ecosystem (PROSE) can improve vision and comfort in patients with persistent epithelial defects. PROSE promotes healing due to its high oxygen permeability, fluid-filled reservoir, reduced corneal contact, positional stability, and protection from lid-related shear forces. Rates of infectious keratitis associated with PROSE have been reduced with the addition of non-preserved Moxifloxacin to the PROSE device reservoir [9].
Surgery
Temporary or permanent punctal occlusion is considered safe and improves corneal staining and symptoms of dry eye in patients with ocular GVHD [10]. In refractory cases, tarsorrhapy may be indicated to decrease exposure, minimize dryness, and reduce the risk of complications associated with exposure keratopathy such as corneal infection, ulceration, and perforation [11]. Patients may benefit from transplantation with multilayer amniotic membrane for severe dry eye [12].
Formation of descemetocele in severe cases of ocular GVHD may require deep anterior lamellar keratoplasty (DALK) or penetrating keratoplasty (PK) [13]. DALK involves removal of the corneal stroma with preservation of host Descemet’s membrane and endothelium. DALK is most useful for the treatment of corneal disease in the setting of a normally functioning endothelium. PK, involving a full-thickness corneal graft, has been the treatment of choice for corneal stromal diseases. PK can be complicated by graft rejection, irregular astigmatism and corneal opacification. DALK may reduce these risks due to preservation of the recipients Descemet’s membrane and endothelium [14].
Medical and Surgical Follow-up
Ocular GVHD is a chronic condition, patients should be followed routinely to monitor and treat dry eye and other complications such as keratitis, cataracts, or ocular hypertension/glaucoma.
Complications
Due to lacrimal gland fibrosis and irreversible dysfunction, patients with aqueous tear deficiency secondary to ocular GVHD rarely have normal tear function after years of follow-up. Numerous complications such as punctate keratitis, corneal filaments, persistent epithelial defects, corneal keratinization, corneal ulceration, and corneal perforation may develop despite adequate tear replacements [3][15] [16]. Ocular proptosis and extra ocular motility limitation have also been described secondary to extraocular muscle infiltration and enlargement, and orbital imaging is important to rule out recurrent malignancy. [17].
References
- ↑ 1.0 1.1 Nassiri N et al. Ocular Graft Versus Host Disease Following Allogeneic Stem Cell Transplantation: A Review of Current Knowledge and Recommendations. Journal of Ophthalmic and Vision Research. 2013; 8(4): 351-358.
- ↑ 2.0 2.1 Couriel D. et al. Ancillary therapy and supportive care of chronic graft-versus host disease: national institutes of health consensus development project on criteria for clinical trials in chronic graft-versus host disease: V. Ancillary Therapy and Supportive Care Working Group Project. Biology of Blood and Marrow Transplantation. 2006; 12(4):375–396.
- ↑ 3.0 3.1 3.2 3.3 Nassar A, Tabbara KF, Aljurf M. Ocular manifestations of graft-versus-host-disease. Saudi Journal of Ophthalmology. 2013; 27 (3): 215–222.
- ↑ Ryu et al. Therapeutic Effect of 0.03% Tacrolimus Ointment for Ocular Graft versus Host Disease and Vernal Keratoconjunctivitis. Korean Journal of Ophthalmology. 2012; 26(4):241-247.
- ↑ Wang Y et al. Ocular surface and tear functions after topical cyclosporine treatment in dry eye patients with chronic graft-versus host disease. Bone Marrow Transplant. 2008; 41(3):293-302.
- ↑ Chhabra S et al. Lifitegrast ophthalmic solution for treatment of ocular chronic graft-versus-host disease. Leuk Lymphoma. 2020; 61(4):869-874.
- ↑ Hessen M, Akpek E. Ocular Graft-Versus-Host Disease. in Allergy Clin Immunol. 2012; 12(5):540-547.
- ↑ Kyung-Sun Na and Man Soo Kim. Allogeneic Serum Eye Drops for the Treatment of Dry Eye Patients with Chronic Graft-Versus-Host Disease. Journal of Ocular Pharmacology and Therapeutics. 2012; 28(5): 479-483.
- ↑ Lim P, Ridges R, Jacobs D, Rosenthal P. Treatment of persistent corneal epithelial defect with overnight wear of a prosthetic device for the ocular surface. American Journal of Ophthalmology. 2013; 156(6): 1095-1102.
- ↑ Sabti S et al. Punctal occlusion is safe and efficient for the treatment of keratoconjunctivitis sicca in patient with ocular GVHD. Bone marrow transplantation. 2012; 47: 981-984.
- ↑ Hessen M, Akpek EK. Ocular graft-versus host disease. Current Opinion Allergy and Clinical Immunology. 2012; 12(5): 540-547.
- ↑ Peris-Martínez C et al. Multilayer amniotic membrane transplantation in severe ocular graft versus host disease. European Journal of Ophthalmology. 2001; 11(2): 183-186.
- ↑ Holland EJ, Mannis MJ, Lee WB. Ocular Surface Disease: Cornea, Conjunctiva, and Tear Film.
- ↑ Söğütlü Sari E, Kubaloğlu A, Ünal M, Piñero Llorens D, Koytak A, Ofluoglu AN, Özertürk Y. Penetrating keratoplasty versus deep anterior lamellar keratoplasty: comparison of optical and visual quality outcomes. British Journal of Ophthalmology. 2012; 96(8):1063-1067.
- ↑ Inagaki E et al. Four cases of corneal perforation in patients with chronic graft versus-host disease. Molecular Vision. 2011; 17:598-606.
- ↑ Stevenson et al. Bilateral corneal ulceration in graft-versus-host disease. Clinical Ophthalmology. 2013; 7: 2153–2158.
- ↑ Proptosis in a Patient With Known Graft Versus Host Disease.Ophthalmic Plast Reconstr Surg.2019; 35(6):e142-e145.